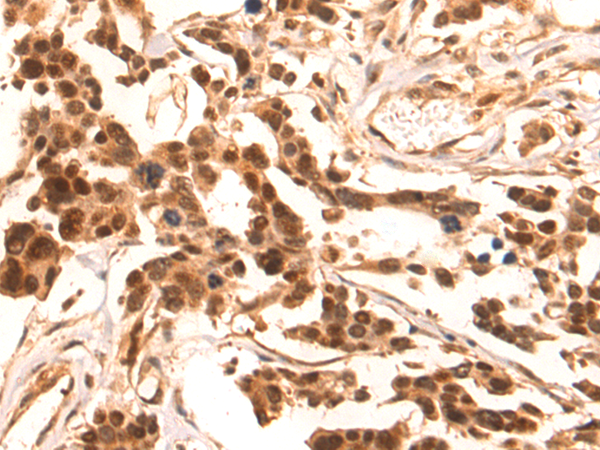
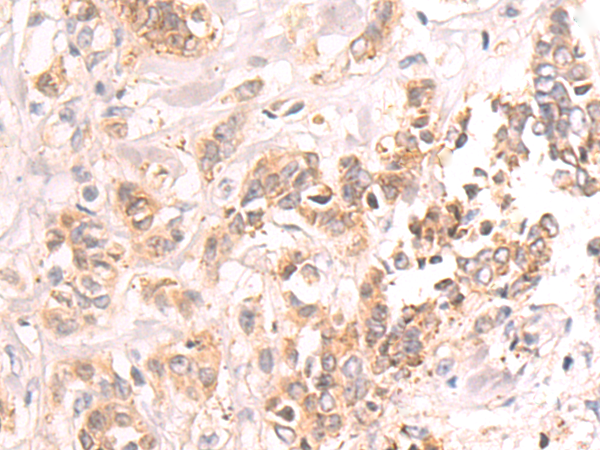

-
分类: 科研抗体货号: P07486别名: NKG2; NKG2A; CD159A应用: IHC反应种属: Human
-
分类: 科研抗体货号: P07505别名: ODC应用: IHC反应种属: Human, Mouse, Rat
-
分类: 科研抗体货号: P07485别名: NK2; NPK; NKNA; TAC2; Hs.2563应用: IHC反应种属: Human, Mouse, Rat
-
分类: 科研抗体货号: P07504别名: OCT2; OTF2; Oct-2应用: WB,IHC反应种属: Human, Mouse
-
分类: 科研抗体货号: P07484别名: HS; NIK; HSNIK; FTDCR1B应用: WB,IHC反应种属: Human, Mouse
-
分类: 科研抗体货号: P07503别名: OCT1, OTF1, oct-1B应用: WB,IHC反应种属: Human, Mouse
-
分类: 科研抗体货号: P07483别名: ngn3; Atoh5; NGN-3; Math4B; bHLHa7应用: WB,IHC反应种属: Human
-
分类: 科研抗体货号: P07501别名: OASLd, TRIP14, TRIP-14, p59OASL, p59 OASL, p59-OASL应用: IHC反应种属: Human
-
分类: 科研抗体货号: P07482别名: NGFB; HSAN5; Beta-NGF应用: IHC反应种属: Human, Mouse, Rat
-
分类: 科研抗体货号: P07499别名: NOT; RNR1; HZF-3; NURR1; TINUR应用: IHC反应种属: Human, Mouse, Rat

鄂公网安备42018502007531号
鄂公网安备42018502007531号

